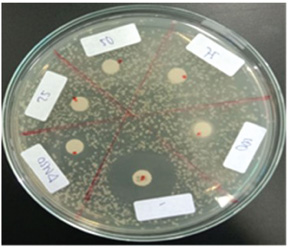

| Research Article | ||
Open Vet. J.. 2025; 15(8): 3590-3597 Open Veterinary Journal, (2025), Vol. 15(8): 3590-3597 Research Article Effects of coconut oil (Cocos nucifera L.) on Aeromonas hydrophila infection, immune protein profile, and mortality in zebrafish (Danio rerio)Dahliatul Qosimah1*, Izuwa Iwanegbe2, Yudit Oktanella3, Nanda Ayu Cindyasputri4, Rahayu Sutrisno5 and Moh. Awaludin Adam61Department of Veterinary and Immunology, Faculty of Veterinary Medicine, Universitas Brawijaya, Malang, Indonesia 2Department of Food Science and Nutrition, Faculty of Agriculture, University of Benin, Benin City, Nigeria 3Department of Veterinary Reproduction, Faculty of Veterinary Medicine, Universitas Brawijaya, Malang, Indonesia 4Faculty of Veterinary Medicine, Universitas Brawijaya, Malang, Indonesia 5Faculty of Health Sciences, Universitas Brawijaya, Malang, Indonesia 6Research Center for Marine and Land Bioindustry / Research Center for Marine Aquaculture, BRIN, Indonesia *Corresponding Author: Dahliatul Qosimah. Laboratory of Veterinary Microbiology and Immunology, Faculty of Veterinary Medicine, Brawijaya University, Malang, Indonesia. Email: dahlia_qosimah [at] ub.ac.id Submitted: 28/04/2025 Revised: 30/06/2025 Accepted: 14/07/2025 Published: 31/08/2025 © 2025 Open Veterinary Journal
ABSTRACTBackground: When fish are immunosuppressed by handling stress, water quality, parasitism, or population density, they develop Aeromonosis. Aeromonas hydrophila is a Gram-negative bacterium that is found in water and can infect fish, frogs, and mammals, including humans. Aeromonas hydrophila is a major pathogen in freshwater aquaculture, causing significant economic losses and raising concerns about antimicrobial resistance due to excessive antibiotic use. Coconut oil, rich in lauric acid, has potential as a natural immunomodulatory feed additive. Aim: This study aimed to investigate the antibacterial effects of coconut oil against A. hydrophila through in vitro assays, assess its impact on zebrafish mortality and gut microbiota in vivo, and explore changes in immune-related protein profiles using Sodium Dodecyl Sulfate - Polyacrylamide Gel Electrophoresis (SDS-PAGE) analysis. Method: A post-test-only control group design was applied, utilizing 225 zebrafish divided into five groups. Three experimental groups received coconut oil-enriched diets at doses of 1,000, 2,000, and 4,000 mg/kg over a 60-day period, followed by immersion challenges with c (10⁸ CFU/ml). Antibacterial activity was evaluated using the disc diffusion method. Gut microbiota, including lactic acid bacteria, were isolated and identified on selective media, and protein expression profiling was conducted via SDS-PAGE. Result: Coconut oil did not demonstrate direct antibacterial effects against A. hydrophila up to 100% concentration. Nevertheless, zebrafish in groups T1 (1,000 mg/kg) and T3 (4,000 mg/kg) exhibited lower mortality rates compared to the positive control. Gut microbiota analyses identified A. hydrophila, Staphylococcus aureus, Pseudomonas aeruginosa, and Lactobacillus spp. SDS-PAGE revealed bands corresponding to proteins at approximately 85–90 kDa [likely heat shock proteins (HSPs)], 27.2–38 kDa (outer membrane proteins), and 44–48 kDa [epidermal growth factor (EGF)-like proteins]. Notably, T1 and T3 groups showed stronger EGF-like bands and a more stable gut microbiota profile, marked by elevated counts of Lactobacillus spp. Conclusion: Coconut oil lacks direct bactericidal activity against A. hydrophila but enhances host resistance by stabilizing gut microbiota and promoting the expression of defensive proteins such as HSP90 and EGF-like molecules. These findings highlight the potential of coconut oil as a non-antibiotic functional feed additive for sustainable aquaculture. Further large-scale and long-term studies are warranted to validate its efficacy. Keywords: Aeromonas hydrophila, Coconut oil, Defensive proteins, Immunomodulation, Gut microbiota. IntroductionAeromonas hydrophila is an opportunistic pathogen that causes serious disease in freshwater fish, including zebrafish, manifesting in hemorrhagic lesions, abdominal distension, and internal organ damage, ultimately leading to high mortality rates and significant economic losses in the aquaculture industry (Okon et al., 2023; Qosimah et al., 2023). To control this infection, antibiotics are commonly administered; however, their excessive and uncontrolled use has led to the emergence of antimicrobial resistance, bioaccumulation in aquatic organisms, and environmental contamination (Helmy et al., 2023). Alternative approaches to enhance fish health and reduce antibiotic dependency are thus urgently needed. Among these, the application of functional feed additives derived from natural ingredients, such as coconut oil, has gained attention. Coconut oil is composed of over 60% medium-chain fatty acids (MCFAs), particularly lauric acid, which exhibits antibacterial, antiviral, and immunostimulatory properties (Joshi et al., 2020). In vitro studies have demonstrated that lauric acid possesses antimicrobial activity against a variety of fish pathogens. However, its effectiveness against Gram-negative bacteria remains limited, and it appears to be ineffective against A. hydrophila (Qosimah et al., 2024). In addition, dietary supplementation with coconut oil has been shown to alter the composition of gut microbiota in fish (Rolinec et al., 2020), notably by increasing populations of beneficial lactic acid bacteria, thereby contributing to improved fish health. Coconut oil also plays a role in modulating the non-specific immune response in fish (Garcia et al., 2023) by enhancing phagocytic activity, promoting the production of anti-inflammatory cytokines (Ameena et al., 2024), and stimulating the expression of defensive proteins. Protein profile analysis using SDS-PAGE enables the identification of immune-related protein expression changes, offering insights into the molecular mechanisms underlying the protective effects of coconut oil. This study aimed at evaluating potential of virgin coconut oil as a functional feed additive, to enhance the resistance of zebrafish against A. hydrophila infection, through a multidisciplinary approach that includes (1) assessing the in vitro antibacterial activity of coconut oil against A. hydrophila, (2) analyzing changes in gut microbiota composition, and (3) identifying immune-related protein expression patterns using Sodium Dodecyl Sulfate - Polyacrylamide Gel Electrophoresis (SDS-PAGE). The novelty of this study lies in the use of virgin coconut oil as a single-agent intervention to investigate its protective mechanisms. The findings are expected to provide a scientific basis for the development of non-antibiotic functional feed strategies that promote fish health and support sustainable aquaculture practices. Materials and MethodsResearch designThis study employed a true experimental post-test-only control group design. Zebrafish (Danio rerio) were divided into five treatment groups: (1) negative control (no infection and no coconut oil supplementation); (2) positive control (infected with A. hydrophila without coconut oil); and (T1, T2, T3), all infected with A. hydrophila and fed diets containing coconut oil at doses of 1,000, 2,000, and 4,000 mg/kg of feed, respectively. Each group included three replicates, with 15 fish per replicate, total of 225 fish. The zebrafish used were mixed-sex, aged 3–5 months, weighing approximately 0.3–0.5 g, and measuring 2.5–3.0 cm in length. Preparation of experimental feedThe basal diet consisted of PF 500 pellets (Prima Feed®, Indonesia), which were finely ground and mixed with virgin coconut oil according to the specified dosages. The mixture was then homogenized and oven-dried at 60°C for 15 minutes (Adelina et al., 2021) to reduce moisture content. The feed was stored in sealed containers and administered twice daily throughout the treatment period. Zebrafish maintenance and acclimatizationZebrafish were obtained from the Fish Breeding Laboratory (Reproductive Division, Faculty of Fisheries and Marine Science, Universitas Brawijaya) and acclimatized for 7 days. Rearing containers (7.5 l capacity) were disinfected by soaking in 50 mg/l calcium hypochlorite [Ca(OCl)₂] for 24 hours. After disposal of the chlorinated water, the containers are refilled with fresh water and treated with sodium thiosulfate (Na₂S₂O₃) at a ratio of approximately 7 mg per mg of chlorine to neutralize residual chlorine. Each container housed 15 fish under controlled conditions: temperature 27°C ± 1°C, pH ~ 7, continuous aeration, and a photoperiod of 14 hours light and 10 hours dark (Awan et al., 2018). On the first day of acclimatization, fish were fed live Tubifex worms, a high-protein (37.97%–44.58%) natural feed (Kusuma et al., 2024). Infection preparation and administration of A. hydrophila infectionIn vitro assay (disk diffusion method)Aeromonas hydrophila used in this study was obtained from the Integrated Service Unit of the Fish Health and Environment Testing Center, Serang, Indonesia, and was confirmed through VITEK testing. The bacteria were adjusted to a concentration of 10⁸ CFU/ml and uniformly spread onto Mueller Hinton Agar (MHA, Merck®) plates, following the procedure described by Kebede et al. (2021). Sterile paper disks were impregnated with coconut oil at concentrations of 25%, 50%, 75%, and 100% (v/v) in Tween 80. These disks were placed onto the inoculated MHA plates and incubated at 27°C for 24 hours. Gentamicin was used as the positive control, while 1% Dimethyl Sulfoxide served as the negative control. Inhibition zones were measured in millimeters (mm). The formation of a clear zone surrounding the paper disks indicated that the coconut oil exhibited bactericidal activity against A. hydrophila. Bacterial isolationAeromonas hydrophila was confirmed through Gram staining and biochemical tests. A starter culture was inoculated into Brain Heart Infusion Broth (BHIB, Merck®) and incubated at 27°C for 24 hours (Sherif et al., 2024) to reach a concentration equivalent to McFarland standard 4.0 (1.2 × 10⁹ CFU/ml). Infection performed by immersion, for 18 hours in bacteria concentration on the 61st day, is 108 CFU/ml. Fish showing clinical signs of infection (e.g., dropsy, hemorrhage) were anesthetized and euthanized by hypothermia (0°C–4°C for 60 minutes) (Cao et al., 2024). Intestines were aseptically dissected, and the contents cultured in BHIB (GranuCult®). Subsequent plating was done on Plate Count Agar (Merck®), followed by incubation at 37°C for 24 hours (Cao et al., 2024). Bacterial colonies were identified based on morphological characteristics, Gram staining, and biochemical testing. Lactic acid bacteria were selectively cultured on de Man Rogosa Sharpe Broth and Agar (Merck®) supplemented with 1% CaCO₃ and incubated anaerobically at 37°C for 48 hours (Shakoor et al. 2025). Identification involved Gram staining, catalase testing, and carbohydrate fermentation profiling using glucose, lactose, maltose, mannitol, fructose, and sucrose. Protein profile SDS-PAGEWhole fish samples were homogenized in lysis buffer containing SDS, Tris-HCl (pH 6.8), and protease inhibitors, and then heated at 95°C for 5 minutes. Electrophoresis was performed using 12.5% resolving and 4% stacking polyacrylamide gels. A total of 20 µl of each protein sample was mixed with loading buffer, heated for 5 minutes, and loaded onto the gel. Electrophoresis was run at 100 V for 10 minutes (stacking phase) and 120 V until protein bands were fully separated (resolving phase). Gels were stained with Coomassie Brilliant Blue R-250 for 1–2 hours and destained using a solution of 40% methanol and 10% acetic acid (v/v) until the background was clear. Protein bands were documented using a Gel Doc™ system (Sharma et al., 2021). Protein bands were documented using a Gel Doc™ system. Data analysisFish mortality data analyzed descriptively in the form of percentages. The in vitro inhibition zones were presented as mean ± SD and analyzed using one-way ANOVA followed by Tukey’s post-hoc test with a significance level of p < 0.05 (GraphPad Prism v9.0, GraphPad Software, CA). Protein profile analysis was conducted descriptively based on the presence of bands, which were assessed for their molecular weight, while intestinal flora was analyzed based on morphological characteristics. Ethical approvalThe study received ethical approval from the Research Ethics Committee of Universitas Brawijaya (No. 118-KEP-UB-2024). ResultsClinical symptomsBased on the study, clinical symptoms of A. hydrophila infection in zebrafish are shown in Figure 1. Zebrafish in the negative control group, not infected with A. hydrophila, did not show any signs of illness (A). Fish in the positive control group, infected with A. hydrophila but did not receive coconut oil, showed the most severe clinical signs, including intense hemorrhaging around the gills and head, as well as abdominal distension. Their body coloration appeared significantly paler compared to the negative control group (B). Fish in the T1 group did not exhibit significant clinical symptoms; no visible hemorrhaging or abdominal distension was observed (C). The T2 group showed the most severe damage among all treatment groups (T1 and T3), with gill hemorrhaging, abdominal distension, and pallor, although still milder than the positive control (D). The T3 group showed mild hemorrhaging and slightly pale body coloration (E). Higher doses of coconut oil (1,000 and 4,000 mg/kg) appeared to reduce the severity of infection symptoms. However, the T2 group (2,000 mg/kg) did not show as much symptom improvement as T1 or T3.
Fig. 1. Clinical symptoms of Aeromonas hydrophila infection in zebrafish: negative control group (A), positive control group (B), T1 group (C), T2 group (D), and T3 group (E). Notes: hemorrhage (red arrows), abdominal distension (blue arrows), paleness (green arrows). Fish mortalityThis study showed a mortality rate of 0% in the negative control group and 18% in the positive control group. Meanwhile, mortality rates in groups T1, T2, and T3 were 16%, 20%, and 13%, respectively. Mortality rates in the T1 and T3 groups were lower compared to the positive control, whereas the T2 group showed a higher mortality rate than the positive control, T1, and T3. Confirmation of intestinal floraIsolation and identification results showed the presence of Lactobacillus sp. Bacterial isolation revealed the presence of A. hydrophila, Staphylococcus aureus, Pseudomonas aeruginosa, and Lactobacillus sp. in all groups except the negative control group, in which A. hydrophila was not detected. The presence of Lactobacillus sp. in all groups indicates the presence of normal gut flora. In vitro disk diffusion assayThe results showed that coconut oil at all tested concentrations (25% to 100%) did not inhibit the growth of A. hydrophila in Figure 2. Protein profileBased on Figure 3, major protein bands with significant intensity were observed at molecular weights of 85–90 kDa in all treatment groups and at 27.2–38 and 44–48 kDa in the positive control, T1, T2, and T3 groups.
Fig. 2. Antibacterial activity test of Aeromonas hydrophila using the disk diffusion method. Bacterial growth was observed at all coconut oil concentrations, indicating that coconut oil does not exhibit bacteriostatic properties against A. hydrophila.
Fig. 3. Protein profile of fish after treatment with coconut oil and infection with Aeromonas hydrophila in all treatment groups. Protein profiles from five groups (negative control, positive control, and three coconut oil doses: 1,000, 2,000, and 4,000 mg/kg feed) are shown using SDS-PAGE, as indicated by arrows. DiscussionThe coconut oil analyzed in this study using gas chromatography flame ionization detector revealed a lauric acid (C12:0) content of 48.96%. Other identified fatty acids included myristic acid (C14:0, 19.50%), palmitic acid (C16:0, 9.04%), caprylic acid (C8:0, 6.39%), capric acid (C10:0, 5.48%), oleic acid (C18:1, 5.80%), and stearic acid (C18:0, 2.79%). Overall, the coconut oil contained 92.85% saturated fats and 1.24% linoleic acid. The high concentration of lauric acid is believed to be closely related to the oil’s immunomodulatory potential and antimicrobial properties. Lauric acid (Suryani et al., 2020) and its monoglyceride, monolaurin, have been reported to possess antimicrobial activity against various Gram-positive and Gram-negative bacteria (Joshi et al., 2020). However, the results of this study demonstrated that coconut oil at concentrations ranging from 25% to 100% did not produce any inhibition zones against A. hydrophila. This suggests a lack of bacteriostatic effect. The inability of coconut oil to inhibit A. hydrophila may be attributed to the bacterial outer membrane, which acts as a barrier against hydrophobic compounds (Vergalli et al., 2020), such as the fatty acids present in coconut oil. This finding is consistent with the statement by Sharma et al. (2019), who explained that the outer membrane and efflux pumps of Gram-negative bacteria hinder the penetration of lauric acid. Although lauric acid is known for its antimicrobial activity against certain pathogens, it appears ineffective against A. hydrophila. It is possible that A. hydrophila possesses an efficient efflux system capable of expelling antimicrobial compounds (Awan et al., 2018). Coconut oil has also been reported to have antifungal activity against Candida albicans (Divyadharsini et al., 2022), indicating that antimicrobial effectiveness can vary depending on the pathogen species. Other factors that may contribute to the lack of antibacterial activity of coconut oil can be classified into two groups. (a) Variations in the fatty acid composition of the coconut oil used, which can influence its antimicrobial activity (Casillas-Vargas et al., 2021), and (b) experimental conditions such as temperature, pH, and incubation time, which may also affect the efficacy of coconut oil as an antimicrobial agent (Yoon et al., 2018). According to Shilling et al. (2013), combining coconut oil with other compounds enhances its inhibitory effects against Gram-negative bacteria. However, this study did not employ any additional combinations. Interestingly, in infected zebrafish, the administration of coconut oil significantly reduced mortality in T1 and T3 groups compared to the untreated group. Mellouk et al. (2024) reported that supplementation with glycerides of lauric acid in poultry enhanced both humoral and cellular immune responses against viral infections, including increased macrophage activation, IFN-γ secretion, and T lymphocyte differentiation into T-helper 1 and Th17 pathways. These mechanisms are closely linked to the upregulation of Tool-Like Receptor 4 and Nuclear Factor kappa-light-chain-enhancer of activated B cells pathways, as well as the expression of pro-inflammatory cytokines such as IL-12 and IL-6, which are important in defense against Gram-negative bacteria such as A. hydrophila. Moreover, in the insect model Drosophila melanogaster, lauric acid and other eicosanoid precursors such as linoleic acid have been shown to enhance antimicrobial peptide (AMP) production and the phagocytic activity of hemocytes, which are functional analogs of macrophages in vertebrates (Azizpor et al., 2024). In this study, A. hydrophila, S. aureus, P. aeruginosa, and Lactobacillus spp. were detected in the fish. The presence of A. hydrophila in all treatment groups confirms that the pathogen was not eliminated, yet the lower mortality rates in T1 and T3 suggest a non-bactericidal mechanism of action. Although coconut oil did not eradicate A. hydrophila from the gastrointestinal tract, it is presumed to have contributed to enhancing the stability of the normal gut flora (Lactobacillus spp.) or reducing the virulence of A. hydrophila, as evidenced by the decreased mortality. Nearly all groups exhibited colonies of lactic acid bacteria, primarily Lactobacillus spp. Notably, group T1 showed the highest count of lactic acid bacteria (CFU/g) (3.02 ± 0.07), compared to T2 (1.38 ± 0.05) and T3 (1.21 ± 0.03) (data not published), suggesting a more stable gut microecosystem in this group. Such microbial stability likely supports the non-specific immune system and inhibits the colonization of opportunistic pathogens such as Pseudomonas and Staphylococcus, thereby reducing fish mortality. Ullah et al. (2025) reported that glycerol monolaurate, a derivative of lauric acid also found in coconut oil, significantly enhanced intestinal integrity, goblet cell numbers, and claudin-1 gene expression, as well as improved the gut microbiota diversity in Acanthopagrus schlegelii. Similar findings were reported by Li et al. (2023), who demonstrated that dominant flora such as Lactobacillus spp and Bifidobacterium spp. can suppress pathogen colonization, reduce pro-inflammatory cytokine production, and maintain gastrointestinal homeostasis through immune modulation along the gut-brain axis. Lauric acid may disrupt bacterial membrane integrity, inhibit virulence enzymes, and stimulate the release of AMPs via activation of TLR and NF-κB pathways (Di Vincenzo et al., 2024). Additionally, this fatty acid can promote mucin expression and strengthen epithelial tight junctions, contributing to gut barrier enhancement (Seo et al., 2021). Furthermore, malondialdehyde, a biomarker of oxidative stress, was found to be highest in T2, whereas T1 and T3 exhibited lower MDA levels (data not documented). Elevated MDA in T2 indicates increased free radical activity, leading to cellular damage and higher mortality. This underscores the impact of an imbalance between oxidative stress and immune defense—exemplified by reduced lactic acid bacterial counts—on the health condition of the fish. Conversely, T1 and T3 exhibited an ideal combination of stable gut microbiota (higher Lactobacillus levels) and lower oxidative stress (low MDA levels), which may explain the reduced mortality observed. Lauric acid, classified as an MCFA, is known for its antioxidant and anti-inflammatory properties, which help mitigate oxidative stress in various animal models. A study by Ameena et al. (2024) revealed that lauric acid can decrease MDA levels, reduce superoxide accumulation, and prevent depletion of endogenous antioxidants, including glutathione and key antioxidant enzymes such as superoxide dismutase and catalase. Protein band analysis revealed the presence of 85–90 kDa bands corresponding to heat shock proteins (HSPs), as described by Han et al. (2020), across all treatment groups, indicating a common cellular response to stress. Protein bands with molecular weights of 27.2–38 kDa correspond to the outer membrane proteins (OMPs) of A. hydrophila (Witkowska et al., 2006), confirming the presence of pathogen–host interactions in infected groups. Bands of 44–48 kDa, identified as epidermal growth factor (EGF) proteins (Widjiati et al., 2012), were observed in the positive controls, T1, T2, and T3, but were absent in the negative control. The presence of EGF supports tissue regeneration processes following injury or hemorrhage (Vaidyanathan, 2021). In T2, the OMP band intensity remained relatively unchanged, and EGF expression was moderate. In contrast, T1 and T3 exhibited clearer EGF expression and a reduction in OMP band intensity, which correlated with lower mortality. This finding suggests a relationship between changes in protein profiles (cellular protection and tissue repair) and the alleviation of clinical symptoms. Coconut oil demonstrates potential as an immunoprotective feed additive. Its lauric acid and saturated fat content contribute to the enhancement of non-specific immune responses, stabilization of gut microbiota, and reduction of oxidative stress. These effects are reflected in the lower MDA levels, higher Lactobacillus counts, and expression of HSP90 and EGF observed in T1 and T3. Conversely, T2 showed increased MDA levels, lower Lactobacillus counts, and the highest mortality rate, indicating suboptimal immune and physiological responses at the intermediate dose. These findings suggest that the immunomodulatory mechanism is key to the success of coconut oil-supplemented diets in responding to A. hydrophila infection. This represents a novel approach, as most herbal-based strategies primarily focus on direct antibacterial effects. In contrast, this study emphasizes the enhancement of host resilience. This study highlights the potential of coconut oil as a non-antibiotic alternative in aquaculture diets. By enhancing host immune defenses, stabilizing gut microecosystems, and mitigating oxidative stress, coconut oil contributes to reduced fish mortality and improved resistance to A. hydrophila infection. Therefore, coconut oil may serve as a strategic feed additive to reduce antibiotic dependency in aquaculture and minimize antimicrobial resistance risks. Further studies should validate protein expression through techniques such as Western blotting or Liquid Chromatography - Tandem Mass Spectrometry and assess long-term effects on growth performance and reproductive capacity. Additionally, a comprehensive analysis of gut microbiota using metagenomic approaches, along with cytokine profiling, is recommended to elucidate the precise immunomodulatory mechanisms of coconut oil in fish health enhancement. ConclusionCoconut oil acts as an immune stimulant feed additive rather than a direct antibacterial agent, supporting the host’s defense response against A. hydrophila infection. While it does not exhibit direct bactericidal activity against A. hydrophila in vitro, it significantly reduces zebrafish mortality in vivo through non-bactericidal mechanisms. Dietary supplementation with coconut oil at doses of 1,000 and 4,000 mg/kg feeds helped maintain gut micro ecosystem stability, contributing to enhanced fish resilience. SDS-PAGE analysis revealed the presence of protein bands at approximately 85–90 kDa (HSP), 27.2–38 kDa (OMP of A. hydrophila), and 44–48 kDa (EGF-like proteins). T1 and T3 groups demonstrated optimal biological responses, as indicated by a more complete profile of defensive proteins, which correlated with the lowest mortality rates. Conflicts of interestThe authors declare no conflicts of interest related to the research, authorship, or publication of this article. FundingCollaborative DPP/SPP Grant, Faculty of Veterinary Medicine, Universitas Brawijaya, Indonesia. Contract Number: I734/UN10.F13/2024. Author’s contributionsConceptualization, D.Q.S.; Methodology, D.Q.S.; Validation, D.Q.S, I.I.; Formal Analysis, D.Q.S, I.I, Y.O, N.A.C, R.S, M.A.A.; Investigation, D.Q.S.; Data Curation, D.Q.S, I.I.; Writing—Original Draft Preparation, D.Q.S, I.I.; Writing—Review and Editing, D.Q.S, I.I.; Supervision, D.Q.S, I.I, Y.O, N.A.C, R.S, M.A.A. Ethical approvalThis protocol was approved by the ethics Committee on Institutional Animal Care and Use (Approval No. 118-KEP-UB-2024). Data availabilityThe authors confirm that data supporting the findings of this study are available in the manuscript. ReferencesAdelina, A., Feliatra, F., Siregar, Y.I., Putra, I. and Suharman, I. 2021. Use of chicken feather meal fermented with Bacillus subtilis in diets to increase the digestive enzymes activity and nutrient digestibility of silver pompano Trachinotus blochii (Lacepede, 1801). F1000Res. 10, 25; doi:10.12688/f1000research.26834.2. Ameena, A., Arumugham, M., Ramalingam, K. and Shanmugam, R. 2024. Biomedical applications of lauric acid: a narrative review. Cureus 16(6), e62770; doi:10.7759/cureus.62770. Awan, F., Dong, Y., Wang, N., Liu, J., Ma, K. and Liu, Y. 2018. The fight for invincibility: environmental stress response mechanisms and Aeromonas hydrophila. Microbial. Pathogenesis 116, 135–145; doi:10.1016/j.micpath.2018.01.023. Azizpor, P., Okakpu, O.K., Parks, S.C., Chavez, D., Eyabi, F., Martinez-Beltran, S., Nguyen, S. and Dillman, A.R. 2024. Polyunsaturated fatty acids stimulate immunity and eicosanoid production in Drosophila melanogaster. J. Lipid Res. 65(9), 100608; doi:10.1016/j.jlr.2024.100608. Cao, X., Xiong, H., Fan, Y. and Xiong, L. 2024. Comparing the effects of two culture methods to determine the total heterotrophic bacterial colony count in hospital purified water. J. Epidemiol. Glob. Health 14(1), 184–192; doi:10.1007/s44197-023-00186-1. Casillas-Vargas, G., Ocasio-Malavé, C., Medina, S., Morales-Guzmán, C., Del Valle, R.G., Carballeira, N.M. and Sanabria-Ríos, D.J. 2021. Antibacterial fatty acids: an update of possible mechanisms of action and implications in the development of the next-generation of antibacterial agents. Prog. Lipid Res. 82, 101093; doi:10.1016/j.plipres.2021.101093. Di Vincenzo, F., Del Gaudio, A., Petito, V., Lopetuso, L.R. and Scaldaferri, F. 2024. Gut microbiota, intestinal permeability, and systemic inflammation: a narrative review. Intern. Emerg. Med. 19(2), 275–293; doi:10.1007/s11739-023-03374-w. Divyadharsini, V., UmaMaheswari, T. and Rajeshkumar, S. 2022. Comparison of antifungal activity of probiotics, coconut oil and clotrimazole on candida albicans – an in vitro study. J. Indian Acad. Oral. Med. Radiol. 34(4), 385; doi:10.4103/jiaomr.jiaomr_137_21. Garcia, C., Andersen, C.J. and Blesso, C.N. 2023. The role of lipids in the regulation of immune responses. Nutrients 15(18), 3899; doi:10.3390/nu15183899. Han, B., Luo, J., Jiang, P., Li, Y., Wang, Q., Bai, Y., Chen, J., Wang, J. and Zhang, J. 2020. Inhibition of embryonic HSP 90 function promotes variation of cold tolerance in zebrafish. Front. Genet. 11, 541944; doi:10.3389/fgene.2020.541944. Helmy, Y.A., Taha-Abdelaziz, K., Hawwas, H.A.E.-H., Ghosh, S., AlKafaas, S.S., Moawad, M.M.M., Saied, E.M., Kassem, I.I. and Mawad, A.M.M. 2023. Antimicrobial resistance and recent alternatives to antibiotics for the control of bacterial pathogens with an emphasis on foodborne pathogens. Antibiotics 12(2), 274; doi:10.3390/antibiotics12020274. Joshi, S., Kaushik, V., Gode, V. and Mhaskar, S. 2020. Coconut oil and immunity: what do we really know about it so far? J. Assoc. Physicians India 68(7), 67–72. Kebede, T., Gadisa, E. and Tufa, A. 2021. Antimicrobial activities evaluation and phytochemical screening of some selected medicinal plants: a possible alternative in the treatment of multidrug-resistant microbes. PLoS One 16(3), e0249253; doi:10.1371/journal.pone.0249253. Kusuma, R.O., Sulaiman Dadiono, Muh., Kasprijo, K., Fitriadi, R. and Tere Yeru, T. 2024. Growth of Tilapia (Oreochromis niloticus) juvenile strain Nirwana with different natural feeding. JOABE 2(1), 73–89; doi:10.62521/3bbmwy23. Li, M., Yang, H., Shao, C., Liu, Y., Wen, S. and Tang, L. 2023. Application of dominant gut microbiota promises to replace fecal microbiota transplantation as a new treatment for Alzheimer’s disease. Microorganisms 11(12), 2854; doi:10.3390/microorganisms11122854. Mellouk, A., Michel, V., Lemâle, O., Goossens, T. and Consuegra, J. 2024. Glycerides of lauric acid supplementation in the chicken diet enhances the humoral and cellular immune response to infectious bronchitis virus. Vet. Immunol. Immunopathol. 274, 110802; doi:10.1016/j.vetimm.2024.110802. Okon, E.M., Okocha, R.C., Taiwo, A.B., Michael, F.B. and Bolanle, A.M. 2023. Dynamics of co-infection in fish: a review of pathogen-host interaction and clinical outcome. Fish Shellfish Immunol. Rep. 4, 100096; doi:10.1016/j.fsirep.2023.100096. Qosimah, D., Laminem, L., Setyawati, D. and Mandasari, C. 2024. Harnessing black soldier fly (Hermetia illucens) prepupae against Aeromonas hydrophila: fermentation-based fatty acids production and its bioinformatic assessment. Open Vet. J. 14(3), 902; doi:10.5455/OVJ.2024.v14.i3.18. Qosimah, D., Santoso, S., Maftuch, M., Khotimah, H., Fitri, L.E., Aulanni’am, A. and Suwanti, L.T. 2023. Aeromonas hydrophila induction method in adult zebrafish (Danio rerio) as animal infection models. Vet. World 16, 250–257; doi:10.14202/vetworld.2023.250-257. Rolinec, M., Medo, J., Gábor, M., Miluchová, M., Bíro, D., Šimko, M., Juráček, M., Hanušovský, O., Schubertová, Z. and Gálik, B. 2020. The effect of coconut oil addition to feed of pigs on rectal microbial diversity and bacterial abundance. Animals 10(10), 1764; doi:10.3390/ani10101764. Seo, K., Seo, J., Yeun, J., Choi, H., Kim, Y.-I. and Chang, S.-Y. 2021. The role of mucosal barriers in human gut health. Arch. Pharm. Res. 44(4), 325–341; doi:10.1007/s12272-021-01327-5. Shakoor, G., Akbar, A., Rahman, H.U., Shakoor, M and Khan, N.A. 2025. Probiotic and antimicrobial potential of Lactobacillus acidophilus isolated from the gut of domestic. Pakistan J. Zool. 1-9, 2025; doi: 10.17582/journal.pcz/20240322041146 Sharma, A., Gupta, V. and Pathania, R. 2019. Efflux pump inhibitors for bacterial pathogens: from bench to bedside. Indian J. Med. Res. 149(2), 129; doi:10.4103/ijmr.IJMR_2079_17. Sharma, N., Sharma, R., Rajput, Y.S., Mann, B. and Gandhi, K. 2021. Distinction between glycomacropeptide and β-lactoglobulin with ‘stains all’ dye on tricine SDS-PAGE gels. Food Chem. 340, 127923; doi:10.1016/j.foodchem.2020.127923. Sherif, A.H., Farag, E.A.H. and Mahmoud, A.E. 2024. Temperature fluctuation alters immuno-antioxidant response and enhances the susceptibility of Oreochromis niloticus to Aeromonas hydrophila challenge. Aquacult. Int. 32(2), 2171–2184; doi:10.1007/s10499-023-01263-9. Shilling, M., Matt, L., Rubin, E., Visitacion, M.P., Haller, N.A., Grey, S.F. and Woolverton, C.J. 2013. Antimicrobial effects of virgin coconut oil and its medium-chain fatty acids on Clostridium difficile. J. Med. Food 16(12), 1079–1085; doi:10.1089/jmf.2012.0303. Suryani, S., Sariani, S., Earnestly, F., Marganof, M., Rahmawati, R., Sevindrajuta, S., Mahlia, T.M.I. and Fudholi, A. 2020. A comparative study of virgin coconut oil, coconut oil and palm oil in terms of their active ingredients. Processes 8(4), 402; doi:10.3390/pr8040402. Ullah, S., Feng, F., Zhao, M., Zhang, J. and Shao, Q. 2025. Comparative effects of dietary supplementations with microencapsulated sodium butyrate, glycerol monolaurate and tributyrin on growth, immunity, and gut health in Black Sea Bream. Animals 15(6), 810; doi:10.3390/ani15060810. Vaidyanathan, L. 2021. Growth factors in wound healing – a review. Biomed. Pharmacol. J. 14(3), 1469–1480; doi:10.13005/bpj/2249. Vergalli, J., Bodrenko, I.V., Masi, M., Moynié, L., Acosta-Gutiérrez, S., Naismith, J.H., Davin-Regli, A., Ceccarelli, M., Van Den Berg, B., Winterhalter, M. and Pagès, J.-M. 2020. Porins and small-molecule translocation across the outer membrane of Gram-negative bacteria. Nat. Rev. Microbiol. 18(3), 164–176; doi:10.1038/s41579-019-0294-2. Widjiati, W., Rachmawati, A., Mumpuni, S. and Sektiari, B. 2012. Identifikasi protein epidermal growth factor (Egf) 46 Kda hasil maturasi oosit sapi secara in vitro. J. Kedokt. Hewan. 6(1), 32–35; doi:10.21157/j.ked.hewan.v6i1.734. Witkowska, D., Masłowska, E., Staniszewska, M., Szostko, B., Jankowski, A. and Gamian, A., 2006. Enterobacterial 38-kDa outer membrane protein is an age-dependent molecular marker of innate immunity and immunoglobulin deficiency as results from its reactivity with IgG and IgA antibody. FEMS. Immunol. Med. Microbiol. 48(2), 205–214; doi:10.1111/j.1574-695X.2006.00137.x. Yoon, B., Jackman, J., Valle-González, E. and Cho, N.-J. 2018. Antibacterial free fatty acids and monoglycerides: biological activities, experimental testing, and therapeutic applications. IJMS 19(4), 1114; doi:10.3390/ijms19041114 | ||
| How to Cite this Article |
| Pubmed Style Qosimah D, Iwanegbe I, Oktanella Y, Cindyasputri NA, Sutrisno R, Adam MA. Effects of coconut oil (Cocos nucifera L.) on Aeromonas hydrophila infection, immune protein profile, and mortality in zebrafish (Danio rerio). Open Vet. J.. 2025; 15(8): 3590-3597. doi:10.5455/OVJ.2025.v15.i8.21 Web Style Qosimah D, Iwanegbe I, Oktanella Y, Cindyasputri NA, Sutrisno R, Adam MA. Effects of coconut oil (Cocos nucifera L.) on Aeromonas hydrophila infection, immune protein profile, and mortality in zebrafish (Danio rerio). https://www.openveterinaryjournal.com/?mno=254912 [Access: June 22, 2026]. doi:10.5455/OVJ.2025.v15.i8.21 AMA (American Medical Association) Style Qosimah D, Iwanegbe I, Oktanella Y, Cindyasputri NA, Sutrisno R, Adam MA. Effects of coconut oil (Cocos nucifera L.) on Aeromonas hydrophila infection, immune protein profile, and mortality in zebrafish (Danio rerio). Open Vet. J.. 2025; 15(8): 3590-3597. doi:10.5455/OVJ.2025.v15.i8.21 Vancouver/ICMJE Style Qosimah D, Iwanegbe I, Oktanella Y, Cindyasputri NA, Sutrisno R, Adam MA. Effects of coconut oil (Cocos nucifera L.) on Aeromonas hydrophila infection, immune protein profile, and mortality in zebrafish (Danio rerio). Open Vet. J.. (2025), [cited June 22, 2026]; 15(8): 3590-3597. doi:10.5455/OVJ.2025.v15.i8.21 Harvard Style Qosimah, D., Iwanegbe, . I., Oktanella, . Y., Cindyasputri, . N. A., Sutrisno, . R. & Adam, . M. A. (2025) Effects of coconut oil (Cocos nucifera L.) on Aeromonas hydrophila infection, immune protein profile, and mortality in zebrafish (Danio rerio). Open Vet. J., 15 (8), 3590-3597. doi:10.5455/OVJ.2025.v15.i8.21 Turabian Style Qosimah, Dahliatul, Izuwa Iwanegbe, Yudit Oktanella, Nanda Ayu Cindyasputri, Rahayu Sutrisno, and Moh. Awaludin Adam. 2025. Effects of coconut oil (Cocos nucifera L.) on Aeromonas hydrophila infection, immune protein profile, and mortality in zebrafish (Danio rerio). Open Veterinary Journal, 15 (8), 3590-3597. doi:10.5455/OVJ.2025.v15.i8.21 Chicago Style Qosimah, Dahliatul, Izuwa Iwanegbe, Yudit Oktanella, Nanda Ayu Cindyasputri, Rahayu Sutrisno, and Moh. Awaludin Adam. "Effects of coconut oil (Cocos nucifera L.) on Aeromonas hydrophila infection, immune protein profile, and mortality in zebrafish (Danio rerio)." Open Veterinary Journal 15 (2025), 3590-3597. doi:10.5455/OVJ.2025.v15.i8.21 MLA (The Modern Language Association) Style Qosimah, Dahliatul, Izuwa Iwanegbe, Yudit Oktanella, Nanda Ayu Cindyasputri, Rahayu Sutrisno, and Moh. Awaludin Adam. "Effects of coconut oil (Cocos nucifera L.) on Aeromonas hydrophila infection, immune protein profile, and mortality in zebrafish (Danio rerio)." Open Veterinary Journal 15.8 (2025), 3590-3597. Print. doi:10.5455/OVJ.2025.v15.i8.21 APA (American Psychological Association) Style Qosimah, D., Iwanegbe, . I., Oktanella, . Y., Cindyasputri, . N. A., Sutrisno, . R. & Adam, . M. A. (2025) Effects of coconut oil (Cocos nucifera L.) on Aeromonas hydrophila infection, immune protein profile, and mortality in zebrafish (Danio rerio). Open Veterinary Journal, 15 (8), 3590-3597. doi:10.5455/OVJ.2025.v15.i8.21 |